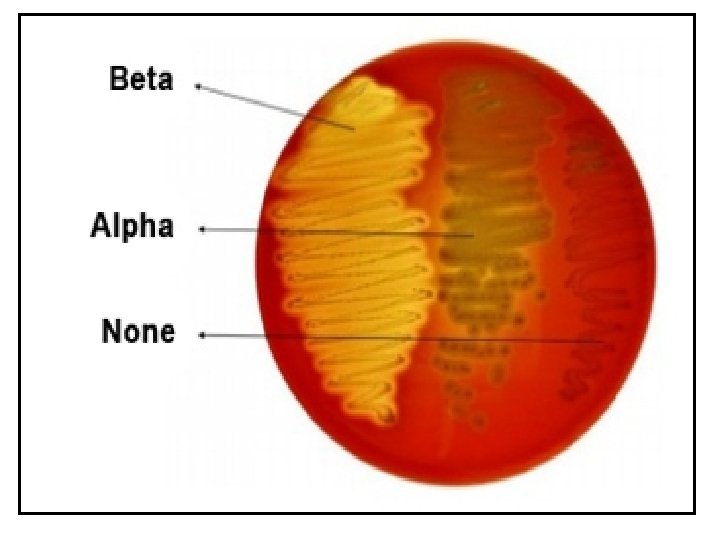
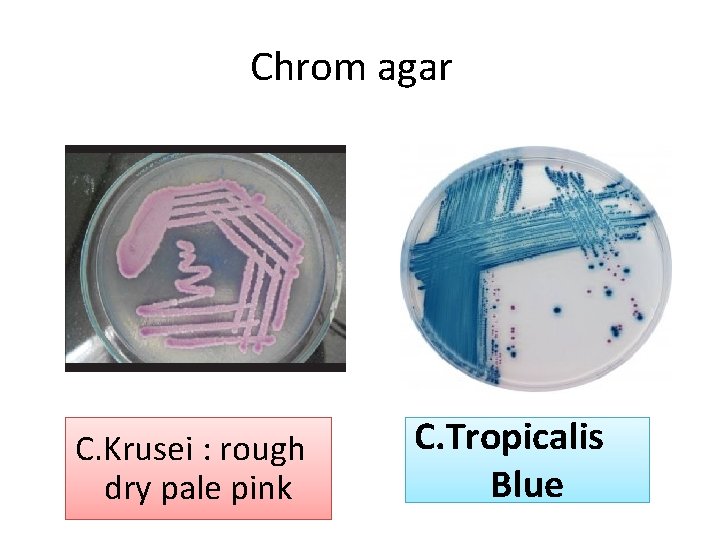
Chrom agar C. Krusei : rough dry pale pink C. Tropicalis Blue

Respiratory system Microbiology laboratory section Gram Positive Coccus

Respiratory system Microbiology laboratory section

Gram Positive Coccus Staphylococcus Spp. Streptococcus Spp.

Staphylococcus Streptococcus

A- staphylococcus. albus B- staphylococcus. Aureus Blood agar

Test for differentiation of Staphylococcus species Catalase test MSA Coagulase

Catalase test

MSA Mannitol salt agar media s u e r. au S S. al bus

S. aureus S. albus


Hemolysis on sheep blood agar

Streptococcus pneumoniae

Streptococcus viridans



Gamma hemolysis streptococcus Entero coccus Group D E. feac Other than Enterococcus group D


Diphtheroids Gram Positive Cocco-bacilli Arrangement as Chinese letter

Candida Species C. albicans C. Krusei Candida Spp. C. glabrata C. tropicalis

Candida Spp • Larger than Bacteria • Budding

sabouraud dextrose agar

To Differentiate between C. albican and other Species Germ tube [ Serum + candida ]

2. Chrom agar C. glabrata : violet (dark pink) glistering C. albicans : Green
Chrom agar C. Krusei : rough dry pale pink C. Tropicalis Blue


Aspergillus Niger

Penicillium Spp.


Lowenstein –Jensen Medium • Contain malachite green and egg albumin • Media color : green • Cell show : Rough Tough Buff

Incubation Period = 4 weeks Put the media in covered tubes to avoid drying of media

ziehl neelsen Acid fast stain • Mycobacterium Tuberculosis cell wall are waxed for that reason do heating while staining. • Stain made of : • Carbol fuchsin • Hydrochloric acid alcohol ( 3% HCL ) • Methylen blue


T. B Acid fast stain
- Slides: 35